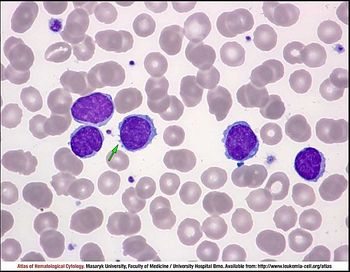

Non-Hodgkin Lymphoma (NHL)
Latest News

Phase 2 Study Shows Feasibility of Axi-Cel Delivery in Outpatient Setting

Indirect Comparison Finds Zanubrutinib Associated With Better PFS, OS Than Acalabrutinib in MCL
Latest Videos

Podcasts
CME Content
More News

In vivo CAR T-cell therapies promise to revolutionize cancer treatment, enhancing access and reducing costs while addressing financial toxicity and logistical barriers.

Study reveals one-third of mantle cell lymphoma patients in a study at leading cancer centers experienced disease progression after CAR T-cell therapy, highlighting treatment challenges and outcomes.

ImmunityBio's study reveals promising results for chemotherapy-free CD19 CAR NK cell therapy in treating Waldenström macroglobulinemia, offering hope for patients.

Researchers at Sylvester Comprehensive Cancer Center reveal how body composition analysis predicts treatment response in diffuse large B-cell lymphoma (DLBCL), enhancing precision medicine strategies.

Brentuximab vedotin combined with cyclophosphamide, doxorubicin, and prednisone (CHP) shows promising results as a first-line treatment in newly diagnosed peripheral T-cell lymphoma (PTCL).

The FDA determined the data from STARGLO did not provide sufficient evidence to support approving glofitamab-gxbm (Columvi) in combination with gemcitabine and oxaliplatin to treat relapsed/refractory diffuse large B-cell lymphoma (DLBCL).

Mantle cell lymphoma treatment offers options if patients relapse after CAR T-cell therapy, from bispecific antibodies, antibody drug conjugates, and other emerging therapies.

Real-world analysis reveals that undetectable CD20 expression worsens outcomes for patients treated with epcoritamab and glofitamab bispecific antibodies for their diffuse large B-cell lymphoma (DLBCL).

In a cohort of TRANSCEND FL, the chimeric antigen receptor T-cell therapy liso-cel showed a 95% overall response rate in relapsed marginal zone lymphoma, offering hope for improved patient outcomes in challenging cases.

Coverage from IVBM Cleveland, held May 15, 2025.

Epcoritamab Plus Chemoimmunotherapy Yields 87% Response Rate in R/R DLBCL; 65% Proceed to Transplant
Results show the regimen of epcoritamab plus R-ICE could serve most patients as a bridge to either autologous stem cell transplant or CAR T-cell therapy.

A post-hoc analysis of EPCORE-NHL-1 was presented at ASCO.

Subcutaneous mosunetuzumab shows promising efficacy and safety in high-tumor burden follicular lymphoma, paving the way for outpatient treatment options.

TP53 aberrations and circulating tumor DNA burden were found to be predictors of poor outcomes in high-risk patients with large B-cell lymphoma.

The findings suggest assessment of CD20 may be an important factor in determining treatment options in B-cell lymphomas.

Elevated LDH and higher international prognostic index were also predictors of poor outcomes on bispecific antibodies, investigators found.

A systematic review and subsequent expert review gave comprehensive insight into prognostic factors for patients receiving treatment for relapsed or refractory diffuse large B-cell lymphoma (DLBCL).

Multidisciplinary efforts help promote the success of clinical trials and innovation for patients with various forms of lymphoma, explained Andrew Evens, DO.

To better treat adolescent and young adult (AYA) patients with various subtypes of Hodgkin and non-Hodgkin lymphomas (NHL), Andrew Evens, DO, speaks to the importance of primary care, screening access, and research.

A majority of cases of diffuse large B-cell lymphoma (DLBCL), the most common type of non-Hodgkin lymphoma globally, are diagnosed in patients 65 years and older; these patients are a heterogeneous group, and few studies have investigated how their outcomes are influenced by patient characteristics and care management regimens.

In this comparative analysis, patients with relapsed/refractory large B-cell lymphoma (R/R LBCL) received bridging therapy via radiation or systemic treatment while their chimeric antigen receptor T-cell therapy (CAR T) was being manufactured.

The American Society of Hematology (ASH) was already looking to expand its Bridge Grant program when changes to the National Institutes of Health (NIH) funding landscape created greater urgency.

Data incorporated for this study were collected from 9 centers in the UK focused on third-line and beyond chimeric antigen receptor (CAR) T-cell administration in patients with relapsed/refractory large B-cell lymphoma (LBCL).

An early pilot trial suggests that combining atezolizumab (tecectriq) with rituximab (Rituxan), gemcitabine (gemzar) and oxaliplatin (eloxatin; GemOx; R-GemOx+Atezo) could be a well-tolerated and effective treatment option in non-Hodgkin lymphoma.